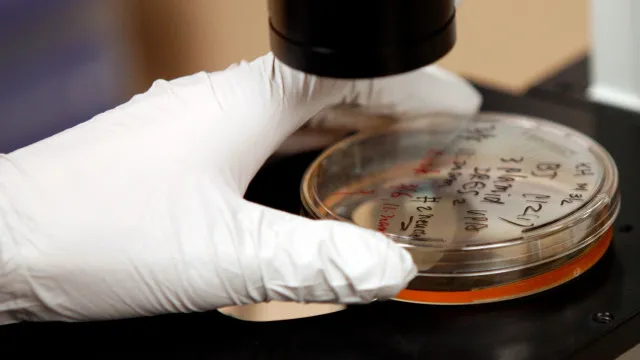

A bactéria que pode causar milhões de casos de câncer
Um estudo recente revelou que uma bactéria comum encontrada no estômago, mas que não apresenta sintomas, pode causar 12 milhões de casos de câncer…
leia mais no Notícias ao Minuto Brasil aqui.